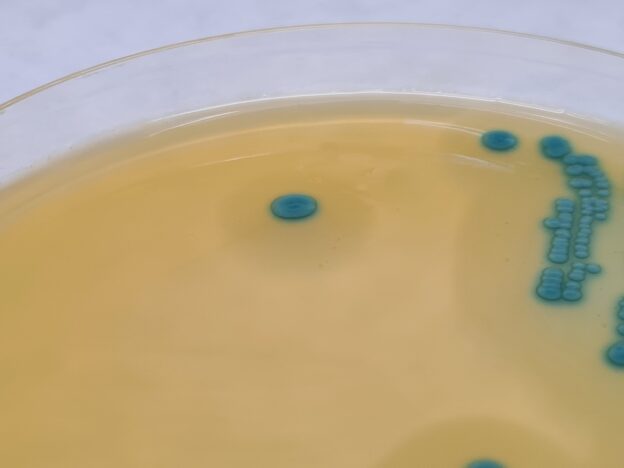

Cepas de Listeria monocytogenes, cepas cuantitativas para el control de los medios de cultivo ISO 11290 según la ISO 11133-2
Listeria monocytogenes es un bacilo Gram positivo de creciente interés en la industria alimentaria, al ser un microorganismo ubicuo que ha provocado múltiples problemas sanitarios, sobre todo en embarazadas y bebés.
Por eso hay ya dos directivas UE que tratan de ella y de las que ya hemos hablado en anteriores artículos.
Las cepas de L.monocytogenes
MICROKIT pone a su disposición la cepa cuantitativa de Listeria monocytogenes en formato lentícula estabilizada (2 años de caducidad desde fabricación), tanto la WDCM 00021 como la WDCM 00109.
Así como la acompañante L.innocua WDCM00017 y la interferente L.ivanovii WDCM 000018.
El medio de referencia sobre el que se debe demostrar el correcto crecimiento típico, es el Ottaviani & Agosti (O&A), medio de origen italiano obligado por la ISO 11290.
Es más conocido por todos como el francés «Aloa».
Y en MICROKIT lo llamamos Cromocytogenes Agar al que fabricamos en España.
Tambien se deben usar estas cepas cuantitativas para controlar la calidad del clásico Agar Palcam.
En las cepas de Listeria de MICROKIT certificamos la concentración de cada lote en TSA y además en O&A.
Listeria monocytogenes crece en O&A con colonias verdes, cóncavas y con halo
Listeria ivanovii tambien crece en O&A con el mismo aspecto que L.monocytogenes en algunas cepas, pero es Rhamnosa- y Xylosa +, mientras L.monocytogenes es Rhamnosa + y Xylosa -.
MICROKIT ofrece el kit preparado de tubos Rhamnosa/Xylosa, esterilizados por filtración para que estos azúcares termolábiles no se desnaturalicen por autoclavado.
Listeria innocua crece en O&A con colonias verdes, pero sin halo.
Otras cepas de Listeria spp
Estas son las concentraciones de estas cepas en el momento de escribir este artículo: (Consúltenoslas antes de realizar sus pedidos, ya que vamos fabricando nuevos lotes cuando se acerca la caducidad de cada cepa, y cada lote tiene concentraciones diferentes).
| Referencia | Cepa | Concentración | CV% | Caducidad |
| WDCM00021 | Listeria monocytogenes SEROVAR 4B ISO 11133-2 PASE 3 LOTE COLOR VERDE LIMA TSA/O&A | (1,52 ± 0,42) x 108 en TSA (1,30 ± 1,0) x 108 en O&A | 20,97 % en TSA
31,90% en O&A |
18-01-26 |
| WDCM00109 | Listeria monocytogenes SEROVAR 1/2a ISO 11133-2 PASE 2 desde colección TIPO ES, LOTE COLOR ESMERALDA, TSA/O&A | (1,72 ± 2,10) x 106 en TSA (1,78 ± 1,22) x 105 en O&A | 47,86% en TSA
41,04% en O&A |
20-04-25 |
| WDCM00017 | Listeria innocua MKTN11288Z LOTE COLOR VERDE AZULADO PASE 1, TSA/O&A (Cromocytogenes Ottaviani & Agosti). Excelente para usar en el recuento de aerobios | (1,42 ± 0,42) x 105 en TSA (1,46 ± 0,54) x 105 en O&A | 20,60% en TSA
23,17% en O&A |
05-10-25 |
| WDCM00018 | Listeria ivanovii (falso + de L.monocytogenes en Agar Ottaviani & Agosti) PASE 3, LOTE COLOR VERDE MENTA TSA/O&A | (8,62 ± 0,98) x 107 en TSA (4,26 ± 3,84) x 107 en O&A | 8,69% en TSA
55,24% en O&A |
30-03-25 |
Consulte el folleto:
https://www.microkit.es/pdf/CEPAS-CUANTITATIVAS-2022.pdf
Y el video:
Haga sus consultas de stocks, concentraciones, caducidades… de nuestras cepas cuantitativas de Listeria spp.y otras muchas en: microkit@microkit.es
Solicite asesoría técnica sobre qué cepas funcionarán mejor en sus muestras (según los resultados de 2 décadas de servicios intercomparativos) y en sus validaciones en: consultastecnicas@microkit.es
Haga sus pedidos de cepas en: pedidos@microkit.es
Cepas cuantitativas de MICROKIT, la únicas lentículas cuantitativas fabricadas en España, desde hace más de 15 años, bajo Norma ISO 9001 y siguiendo las directrices sobre la competencia de los fabricantes de material de referencia (ISO 17034).